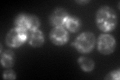
YNL044W
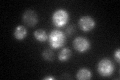
YNL044W

View description
Protein localized to COPII vesicles, proposed to be involved in ER to Golgi transport; interacts with members of the Rab GTPase family and Yip1p; also interacts with Rtn1p
Localization:
Intensity:
Fold change:
Significance:
-
C’ GFP library in SD
punctate109.54 -
N' NOP1pr-GFP in SD

punctate107.291 -
N' TEF2pr-mCherry in SD

punctate261.586 -
N' NATIVEpr-GFP in SD

punctate63.1629 -
N' TEF2pr-VC and Cyto-VN in SD

punctate34.6986 -
C’ GFP library in SD+DTT

punctate441.324.02Yes -
C’ GFP library in SD+H2O2

punctate.cytosolN/AN/ANo -
C’ GFP library in Starvation Media
punctate96.680.88No -
C’ GFP library on the background of Pup2-DaMP

punctate -
C’ GFP library on the background of CCT mutant

punctate99.57690.908974No
